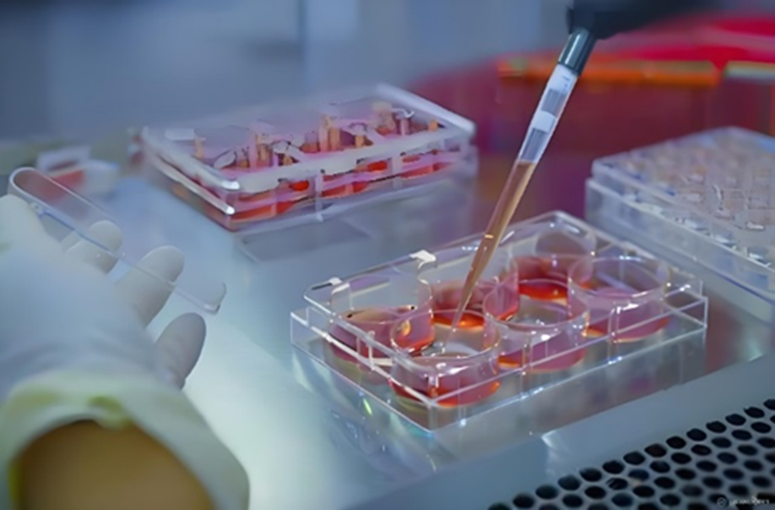
新闻图片1

微信扫一扫
关注公众号
- Western Blot实验试剂 (26)
- 蛋白表达试剂 (9)
- 蛋白/抗原/标准品 (6946)
- 诊断抗体、细胞学产品 (12)
- 重组蛋白表达服务 (15109)
- HRP/FITC/Biotin/胶体金标记抗体、标记试剂盒 (47)
- 染色液系列 (12)
- 抗体纯化试剂 (6)
- ELISA试剂盒、相关试剂 (7929)
- 精品技术服务 (11)
- 细胞融合试剂 (8)
- 实验手册、小仪器 (2)
- 感受态细胞 (36)
- 荧光定量试剂/试剂盒、核酸提取试剂/试剂盒 (9)
- 内参、标签及其他抗体 (17)
- 2019新冠抗体及二抗 (61)
- 工具酶 (8)
- 猴痘抗体 (6)
- 荧光抗体 (25)
- 基孔肯亚病毒抗体/蛋白 (23)
- 其他分类 (14)
【吹爆】杂交瘤细胞培养添加因子让你事半功倍!
发布时间:2026-01-21 14:36 | 点击次数:279
杂交瘤细胞培养中添加因子确实可以事半功倍!
在杂交瘤细胞的培养过程中,添加特定的因子可以显著提升细胞的生长速度、稳定性和活性,从而为单克隆抗体生产和其他生物制品研发带来显著的优势。以下是对这些添加因子的详细解析:
· 生长加速:
效果:添加因子后,杂交瘤细胞的分裂速度会显著提升,仿佛为细胞生长安装了“涡轮增压器”。
原理:这些因子通常包含细胞生长所需的营养成分、生长因子或信号分子,能够刺激细胞进入更快速的增殖周期。
优势:显著缩短细胞培养周期,提高实验效率。
· 稳定性强:
表现:即使在多变的实验室环境中,添加因子后的杂交瘤细胞也能保持稳定的生长状态。
原理:这些因子能够调节细胞内的代谢途径和信号传导,使细胞对外界环境的适应性增强。
优势:减少实验中的不确定性,提高实验结果的可靠性和重复性。
· 数据亮眼:
结果:使用添加因子后,杂交瘤细胞的活性和增殖数据会显著提升,图表上的数据表现令人瞩目。
原理:因子通过促进细胞生长和分裂,增加了细胞数量,从而提高了实验数据的统计显著性。
优势:使研究结果更加具有说服力,有助于发表高质量的科研论文。
· 精准调控:
功能:添加因子能够精准调控杂交瘤细胞的状态,包括生长速度、分化程度和抗体产生能力等。
原理:这些因子通过特定的信号传导途径,对细胞进行精确的调控,使其达到最佳的生长和分化状态。
优势:提高实验结果的准确性和可靠性,有助于深入研究细胞生物学和免疫学机制。
· 适用广泛:
范围:这款添加因子适用于多种杂交瘤细胞系,无论是单克隆抗体生产还是其他生物制品研发,都能发挥显著作用。
灵活性:根据不同的实验需求,可以调整因子的种类和浓度,以达到最佳的实验效果。
优势:为科研人员提供了更多的选择和灵活性,有助于推动科研项目的进展。
图片展示:
(注:图片展示了杂交瘤细胞在添加因子后的生长状态,细胞数量显著增加,形态饱满,表明因子对细胞生长具有显著的促进作用。)

(注:图片展示了使用添加因子后,杂交瘤细胞活性和增殖的数据表现,数据飙升,表明因子对细胞活性和增殖具有显著的促进作用。)
综上所述,杂交瘤细胞培养中添加特定的因子可以显著提升细胞的生长速度、稳定性和活性,为科研人员提供了更多的选择和灵活性,有助于推动科研项目的进展和发表高质量的科研论文。如果你正在从事杂交瘤细胞培养或相关生物制品研发工作,不妨尝试一下这款添加因子,相信它会给你带来意想不到的收获!


